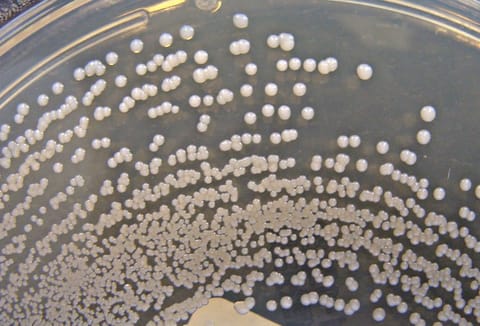

Az antibiotikum-rezisztencia az egyik vezető halálok a világon, globális egészségügyi problémát jelentenek az antibiotikumoknak ellenálló baktériumok. Dán kutatók találtak egy ígéretes módszert, amellyel antibiotikum nélkül irtható ki egy makacs baktériumtörzs.
Minél több antibiotikumot használunk (és bizony használunk), annál jobban ellenállnak egyes baktériumtörzsek ezeknek a gyógyszereknek, ami egyre aggasztóbb problémát vet fel az egészségügyben. A Staphylococcus aureus (egy Gram-pozitív baktérium a Staphylococcus nemzetségből) egyike az ilyen kórokozóknak. Ott él az egészséges ember bőrén, orrjáratában, és általában nm is okoz gondot, azonban ha valakinek lecsökken az immunitása, akkor támadásba lendül, és akár életveszélyes betegségeket is okozhat.
Különösen igaz ez a kórházi környezetben, ahol a S.aureus bejuthat a véráramba a műtétek, illetve az invazív orvosi eszközökön keresztül, és máris fellép a rettegett kórházi fertőzés. Miután ezek a szuperbaktériumok ellenállnak az antibiotikumoknak, az orvosok is tehetetlenek.
A Koppenhágai Egyetem kutatói nemrégiben találtak egy ígéretes módszert az antibiotikum-rezisztens bacik ellen. Laboratóriumi kísérletükben egy olyan enzim (endolizin) mesterséges változatát használták, amelyet bakteriofágok (baktériumokat fertőző vírusok) termelnek, és sikerült kiirtaniuk a Staphylococcus aureust bőrlimfómás betegek biopsziás mintáin. Az említett enzim képes áthatolni a szuperbaktérium falán, ami lehetővé teszi, hogy megcélozza és elpusztítsa a káros staphylococcusokat, és sértetlenül hagyja az ártalmatlan bőrbaktériumokat.
Bár ezeknél a laboratóriumi kísérleteknél műanyag edényekben tartott bőrbiopsziás mintákat használtak, azaz még nem beszélhetünk „igazi” kezelésekről, az eredmények ígéretesek. Ráadásul úgy tűnik, hogy a S.aureus törzsek nem tudnak rezisztenssé válni az endolizinekre.
Ha máskor is tudni szeretne hasonló dolgokról, lájkolja a HVG Tech rovatának tudományos felfedezésekről is hírt adó Facebook-oldalát.